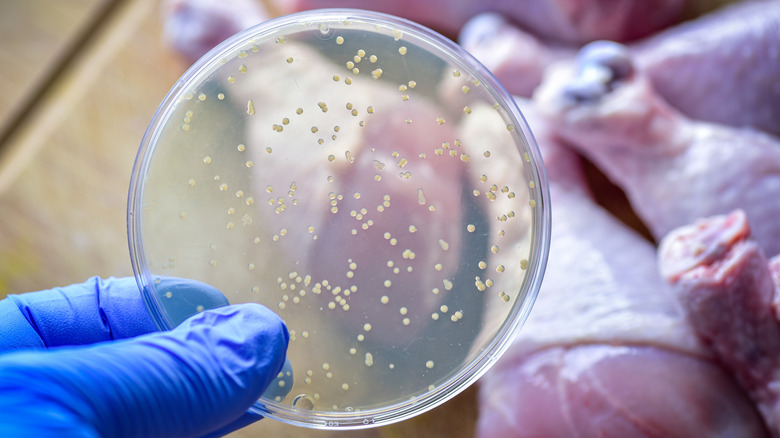

Is There A Difference Between Food Intoxication And Food Poisoning?
It's estimated that the United States sees around 48 million cases of foodborne illness every year, which leads to about 128,000 hospitalizations and 3,000 deaths annually (via the U.S. Food and Drug Administration). Although there are many safeguards in place all over the world, food and drinks still fall victim to contamination from sources such as toxins, chemicals, bacteria, and parasites that can, in turn, contaminate our digestive systems. Foodborne illness, also called foodborne disease, is a blanket term that covers a wide range of intestinal afflictions with remarkably unpleasant symptoms such as stomach pain, nausea, and even fever and weakness — food intoxication and food poisoning included.
In the midst of the experience, you're probably not too worried about a linguistic distinction. But, once you've recovered enough to feel something other than intestinal distress, curiosity might arise and you might wonder what you should call the suffering you just went through. In truth, food poisoning is more of a colloquial term than a scientific one. It's often used for different types of foodborne illness because they cause similar symptoms. The condition that people are typically referring to when they say food poisoning is actually called food intoxication. In some cases, though, people might use food poisoning to refer to the other ailment under the foodborne illness blanket: food infection. The difference between these two comes down to the pathogenic source.
Food intoxication makes you sick to your stomach
Despite what probably came to mind when you first heard it, food intoxication has nothing to do with alcohol. Its name actually hearkens back to the root of the word intoxicate — to poison. Food intoxication happens when harmful bacteria, such as Staphylococcus aureus or Bacillus cereus, get into food or beverages and produce toxins. Staphylococcus aureus, for example, is a bacterium found on human skin and in noses and throats that can be transmitted if the person handling your food doesn't wash their hands properly (it's also exacerbated by room temperature storage).
Bacteria can begin toxin production under circumstances such as improper storage or allowing cooked food to sit too long at room temperature. Generally speaking, the toxins that fall under the food intoxication category generate symptoms more quickly than food infections — sometimes in as little as half an hour — and many run their course in 24 to 48 hours if the infected person is otherwise healthy. Some toxins, though, continue to wreak havoc for as much as a couple of weeks.
Food infection can stay around for longer
Lots of infectious pathogens (whether bacteria, parasites, or viruses) can cause food infection, but symptoms typically take longer to present than those from food intoxication. Symptoms also usually last longer, sometimes returning over months. For example, hepatitis A takes an average of 28 days before it manifests as flu-like symptoms, joint pain, and jaundice and can stay for six months or more. Food infection is also generally more easily spread — think the five worst E. coli outbreaks in United States history and norovirus, which has around 2,500 outbreaks per year in the U.S. and is responsible for 58% of the country's foodborne illnesses, according to the U.S. Centers for Disease Control and Prevention.
The severity of both food infection and food intoxication can vary widely, but even mild cases should be avoided — handling food and beverages safely is essential. There are lots of food safety mistakes you should start avoiding now, including keeping all surfaces, utensils, food, and yourself clean by washing in sanitary water. You should also keep raw meat, seafood, and eggs away from produce and other foods and cook your food to recommended temperatures. Don't forget to properly store it when you're done — pathogens love room temperature. Lastly, if it's expired, old, or moldy, don't risk your intestinal health on the smell test and throw it out.